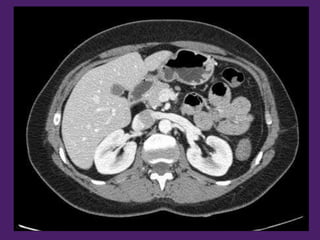
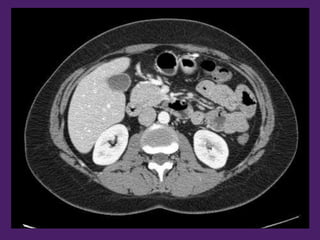

El documento describe la anatomía de las paredes abdominales y el espacio supramesocólico. Detalla los elementos óseos y musculares que forman las paredes abdominales, así como las estructuras que delimitan el abdomen. Además, divide el contenido abdominal en secciones supramesocólica e inframesocólica y presenta múltiples imágenes de cortes transversales del abdomen para ilustrar las estructuras internas.